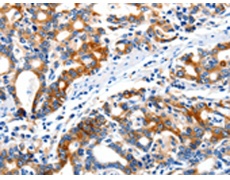
一抗

別 名: CD11C, SLEB6
技術(shù)規(guī)格
|
Background: |
This gene encodes the integrin alpha X chain protein. Integrins are heterodimeric integral membrane proteins composed of an alpha chain and a beta chain. This protein combines with the beta 2 chain (ITGB2) to form a leukocyte-specific integrin referred to as inactivated-C3b (iC3b) receptor 4 (CR4). The alpha X beta 2 complex seems to overlap the properties of the alpha M beta 2 integrin in the adherence of neutrophils and monocytes to stimulated endothelium cells, and in the phagocytosis of complement coated particles. |
|
Applications: |
ELISA, IHC |
|
Name of antibody: |
ITGAX |
|
Immunogen: |
Synthetic peptide of human ITGAX |
|
Full name: |
integrin, alpha X (complement component 3 receptor 4 subunit) |
|
Synonyms: |
CD11C, SLEB6 |
|
SwissProt: |
P20702 |
|
IHC positive control: |
Human gastric cancer |
|
IHC Recommend dilution: |
15-50 |

 購物車
購物車 幫助
幫助
 021-54845833/15800441009
021-54845833/15800441009